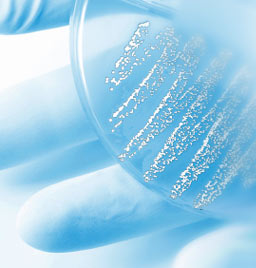

| Viele der von uns angebotenen Leistungen unterliegen strengen gesetzlichen Bestimmungen und setzen hohe fachliche Qualifikationen voraus. | |
| Personalausstattung | Mit hochqualifizierten Mitarbeitern, die über umfassende wissenschaftliche Reputation verfügen, beraten und betreuen wir Sie in allen Fragen der Hygiene kompetent und gründlich. Zu unserem Team gehören Ärzte für Hygiene, Diplombiologen, medizinisch-technische Assistenten und Hygienefachkräfte. |
| Normen und Richtlinien | Wir sind mit allen für unsere Kunden wichtigen Normen und Richtlinien vertraut. U.a. Validierungsrichtlinie der Deutschen Gesellschaft für Krankenhaushygiene DGKH Trinkwasserverordnung DIN 1946 und VDI 6022 für raumlufttechnische Anlagen Verbund für angewandte Hygiene e.V. VAH Richtlinie für Krankenhaushygiene und Infektionsprävention des Robert-Koch-Institutes. |
 |
Wir sind akkreditiert für mikrobiologische Trinkwasseruntersuchungen nach DIN EN ISO/IEC 17025:2005 |
 |
Für Produkte, die aus Sicht der Hygiene besonders sinnvoll sind, vergeben wir auf Antrag und nach Prüfung und Bewertung unserer Jury, dieses Zeichen. |
© 2008 Hygiene-Institut Berlin Search Care GmbH. Alle Rechte vorbehalten. | Impressum | Nutzungsbedingungen